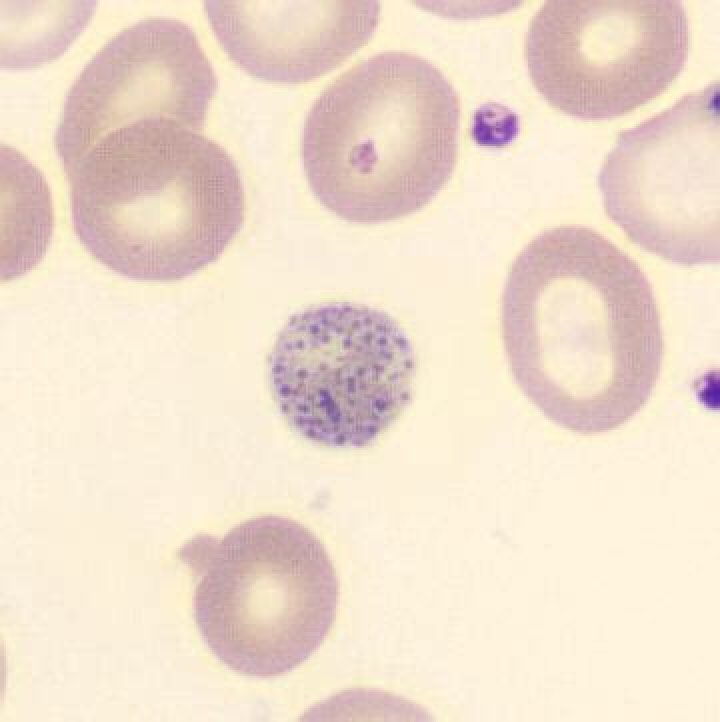

Dacrocytes - How To Discuss
Dacrocytes
What is a tear cell?
Tear droplets (dacrocytes) are often associated with bone marrow infiltrations due to fibrosis, granulomatous inflammation, or haematopoietic or metastatic neoplasia. Tear drops, which act as a blood lubricating artifact, have pointed ends that point in the same direction.
Similarly, what do tear cells mean?
The presence of teardrop-shaped cells can indicate: myelofibrosis. Severe iron deficiency.
Anemia caused by the bone marrow not producing normal blood cells due to toxins or cancer cells (myelophytic process)Secondly, how are tear cells formed?
Tear cells (dacrocytes) are thought to form as a result of removing an inclusion from the cell as it travels through the spleen. This process is known as puncture.
Second, what are tear cells?
A dacryocyte (or dacryocyte) is a type of poikilocyte that is shaped like a droplet (a tear cell). A significant increase in dacrocytosis is called dacrocytosis.
Is poikilocytosis dangerous?
The long-term outlook for poikilocytosis depends on the cause and how quickly you are treated. Iron deficiency anemia can be treated and often treated, but it can be dangerous if left untreated.
What are the causes of abnormally shaped red blood cells?
Sick Anemia
What Causes Oval Blood Cells?
Ovalecites are red blood cells that have an oval shape instead of the usual round donut shape. Eggs are more fragile than normal red blood cells. Hereditary ovalocytosis is a genetic disease that affects the walls of red blood cells and causes the formation of many ovalocytes.
What are Pencil Cells in Blood?
Cigar cells (also called pencil cells) are cigar- or pencil-shaped red blood cells on a peripheral blood smear. However, they can also be seen in iron deficiency anemia and other pathological conditions that reduce red blood cell turnover and production.
What is causing the target cells?
Target cells appear under conditions that cause red blood cell area to increase disproportionately to volume. This may be due to a decrease in hemoglobin, as in iron deficiency anemia, or to an increase in the cell membrane.
What is the name of a teardrop shape?
What are stomatocytes?
Stomatocytes are erythrocytes with a split central pallor that gives them the appearance of coffee beans or kissing lips. Stomatocytes are actually bowl-shaped in three dimensions, as the cell has lost its biconvex morphology due to a membrane defect.
Are drool cells bad?
Having cells in the cage was associated with a mortality rate of 27.3% and was most commonly seen in patients with renal or hepatic insufficiency. Absolute lymphocytosis predicted an unfavorable outcome in patients with trauma and CNS damage.
What is microcytosis1?
Hypochromic microcytic anemia. Hypochrome means that red blood cells have less hemoglobin than normal. Low hemoglobin levels in red blood cells make them appear paler. In microcytic hypochromic anemia, the body has low levels of red blood cells, which are both smaller and paler than normal.
What are Howell Jolly’s bodies?
A Howell-Jolly body is a cytopathological discovery of basophils (groups of DNA) in circulating red blood cells. Presence usually means a damaged or missing spleen, as a healthy spleen would normally filter these types of red blood cells.
What is hypochromic anemia?
What are spherocytes?
Spherocytosis is the presence in the blood of spherocytes, that is, erythrocytes (red blood cells) of a spherical shape rather than two concave normally shaped discs. In all hemolytic anemias, spherocytes are found to some extent.
What does a Pap smear show?
A blood test is a blood test used to check for abnormalities in blood cells. red blood cells that carry oxygen around the body. white blood cells, which help the body fight infections and other inflammatory diseases. Platelets, important for blood clotting.
Are burr cells normal?
Blackberry cells, also called echinocytes, have a mirrored border over the entire cell surface. Burr cells are often found in kidney disease and end-stage liver disease. In our study, Burr cells were found in 80% of healthy people, even though the cell count was very low.
What do the target cells indicate?
The presence of cells called target cells can be caused by: The lack of an enzyme called lecithin cholesterol acyltransferase. Abnormal hemoglobin, the protein in red blood cells that carries oxygen (hemoglobinopathies).
What is Bone Marrow Fibrosis?
What does megaloblast mean?
Megaloblastic anemia is anemia (classified as macrocytosis) caused by the inhibition of DNA synthesis during the production of red blood cells. Lack of DNA synthesis in red blood cells is usually due to hypovitaminosis, particularly a deficiency of vitamin B12 or folate.


